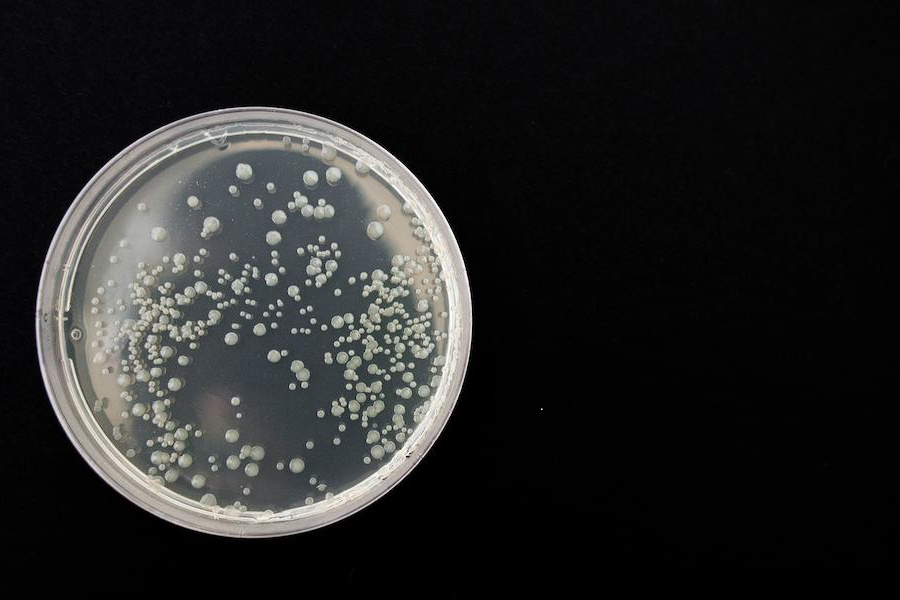

Ihre Expertin für Trinkwasser
Als unabhängige Sachverständige für Trinkwasserhygiene bin ich persönlich für Sie da. Nach einer ausführlichen Systemaufnahme erstelle ich eine Risikoabschätzung (ehem. Gefährdungsanalyse) gemäß der aktuellen Trinkwasserverordnung § 51 Absatz 1 TrinkwV 2023 für Hauseigentümer, Hausverwaltungen, öffentliche Einrichtungen und Betriebe.
Die Erstellung der Risikoabschätzung erfolgt nach der Empfehlung des Umweltbundesamtes vom 14.12.2012. Von der vor Ort Begehung bis zur Abschlussbesprechung werden Sie ausschließlich von mir persönlich betreut.
Durch langjährige Erfahrung im Bereich Trinkwasser und Prozesswasser bin ich Ihr verlässlicher Ansprechpartner für alle Themen rund um Wasserqualität. Aufgrund ständiger Fortbildungen garantiere ich Ihnen aktuelle und fachkundige Beratung.
„Ihr Anliegen ist bei mir in besten Händen – ich stehe Ihnen mit Rat und Tat zur Seite“
Dipl.-Chem. Monika Völkl
Leistungen
Untersuchung auf Legionella spec.
Wasser als Lebensmittel oder als Rohstoff in der Industrie – um höchste Qualität zu erreichen biete ich ein breites Spektrum an Beratungsdienstleistungen
Mikrobiologie
Mikrobiologie Ablagerungen
Ablagerungen Korrosion
Korrosion
Welche Probleme haben Sie mit Ihrem Wasser? Kennen Sie Ihre Wasserqualität?
Die Wasserqualität hat einen entscheidenden Einfluss auf das Geschehen in den Leitungssystemen. Ich erstelle eine ausführliche Systemaufnahme inklusive Wasseranalysen.
Im Anschluss daran erhalten Sie einen ausführlichen Bericht über Ihre aktuelle Situation mit Empfehlungen zur Optimierung der Wasserqualität, um Schäden durch Mikrobiologie, Korrosion und Ablagerungen zu vermeiden. Die Produktivität und Leistung von industriellen Prozessen kann stabilisiert und optimiert werden.
Gerne berate ich Sie und erstelle ein individuelles Angebot zu ihren speziellen Anliegen.
Standorte
Sie können mich für ganz Deutschland anfordern. Für folgende Standorte in Bayern und Baden-Württemberg ohne Anfahrtskosten:
(Reisezeiten werden als Arbeitszeit vergünstigt berechnet)
Straubing – Landshut – Regensburg – Ingolstadt – Deggendorf – Passau – Nürnberg – Augsburg – Ulm – Heilbronn – Stuttgart – Tübingen
Haben Sie noch Fragen?
Ich freue mich von Ihnen zu hören!
Dipl.-Chem. Monika Völkl
Telefon: +49 1575 049 3466
E-Mail: info@isifill.eu
Anschrift: isifill UG, Grafentraubach 791, 84082 Laberweinting, Bayern
Montag – Freitag 8:00 – 16:00 Uhr










